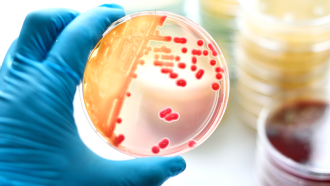
860_main_single_celled_world.ПНГ

Проанализируйте это: какие клетки самые быстрые?
Ячейки быстро перемещаются, прыгая, скользя, плавая и даже расширяясь, как воздушный шар
⏸
Классные ресурсы для этой статьи
- Ключевые слова
Оценка удобочитаемости: 6,7
Коды NGSS:
HS-LS1-2, MS-LS1-1
Жизнь на скоростной трассе может вызвать в памяти бегущих гепардов и пикирующих соколов. Но существует множество демонов скорости, едва заметных невооруженным глазом. Клетки — одни из самых быстрых живых существ на Земле. Если бы эти клетки соревновались в своих собственных Олимпийских играх, кто бы победил? Ученые теперь выяснили, как сложатся некоторые из самых маленьких в мире пловцов, спринтеров и прыгунов с трамплина.
Участники Олимпийских игр по клетчатке не будут появляться одетыми в форму и готовыми к соревнованиям, говорит Ману Пракаш. Он биоинженер и океанограф из Стэнфордского университета в Калифорнии. “Мы должны провести поиск в лужах и прудах по всему миру и в океанских глубинах”, — говорит он. Чтобы сравнить клетки, его команда собрала данные о скорости некоторых из них. Они проанализировали предыдущие данные, которые ученые собрали о других клетках.
Некоторые быстрые клетки прыгают или скользят по воде. Другие размахивают похожими на хлыст нитями, называемыми жгутиками, или плавают с помощью ресничек, похожих на волосы. Кроме того, существуют спидстеры, которые не меняют положения, а сжимаются или расширяются.
В некоторых случаях клетка, являющаяся частью более крупного организма, совершает быстрое перемещение. Это включает в себя стрекательные клетки пресноводной гидры, которые одним выстрелом выделяют токсины. В других случаях одноклеточные формы жизни перемещаются мгновенно.

Во время поездки в Либерию, на Западе В Африке Пракаш увидел бесчисленные белые крапинки в пруду. Они были распределены особым образом. “Это не могло быть случайным”, — говорит он. Он взял образец и обнаружил спиростомум, тип одноклеточного организма. Он может сокращать свое тело быстрее, чем другие эукариоты — организмы, клетки которых заключают свою ДНК в ядро. Быстрое сокращение — это часть коммуникации Spirostomum, говорит Пракаш. “Как мы выяснили позже, он на самом деле общается с другими клетками, используя звук под водой”.
Пояснение: Прокариоты и эукариоты
Или возьмем Pyrocystis. Эти водоросли не плавают, и все же они совершают массовые миграции. Пракаш обнаружил эти клетки глубоко в океане у побережья Гавайев. Сначала это не имело никакого смысла, потому что этим клеткам для фотосинтеза нужен солнечный свет. Но Пракаш и его команда поняли, что водоросли могут раздуваться в пять раз больше своего первоначального размера и сдуваться. Это позволяет клеткам преодолевать расстояние в километр (0,62 мили) от глубины до освещенной солнцем воды.По словам Пракаша, учитывая размер клеток, это самая продолжительная миграция на планете. Он и его коллега по команде Рэй Чанг поделились своим сравнением сверхбыстрых клеток в октябре 2025 года в Ежегодном обзоре микробиологии.
Пракаш обнаружил много быстрых клеток, когда искал жизнь в экстремальных условиях. Эти необычные организмы расширяют наше понимание того, как устроена жизнь. “Эта планета полна абсурда”, — говорит он. “Когда вы можете сравнить эти вещи, вы можете понять степень абсурдности”. И это, по его словам, подчеркивает, как эволюционировали некоторые совершенно особые формы жизни.


На рисунке А показаны скорости некоторых из самых быстрых известных ячеек и то, как они перемещаются. На рисунке В показаны различные размеры клеток (ось x) и максимальная скорость (ось y).
Инфузории передвигаются с помощью волоскоподобных структур, называемых ресничками. Жгутиконосцы передвигаются с помощью хлыстовидных структур, называемых жгутиками. Они совершают многие из тех же самых движений, включая плавание, ходьбу, упругие прыжки (движения за счет сокращения ресничек или жгутиков) или гидродинамические прыжки (используя реснички или жгутики для прыжка вперед).
К прокариотам относятся бактерии и археи. Подвижность, основанная на поверхности, означает, что клетка перемещается вдоль поверхности. Выпячивание клетки или экструзома — это когда что-то выскакивает из клетки. А сокращение без перемещения означает, что размер клетки изменяется, но положение всей клетки остается неизменным.
Клетки, расположенные над пунктирной линией на рисунке В, перемещаются более чем на 10 длин тела в секунду. Ячейки над сплошной линией перемещаются со скоростью более 100 длин тела в секунду.
Загрузка данных:
- Какая ячейка самая быстрая, показанная на рисунке A? Какова ее скорость?
- Какая клетка плавает быстрее всего? Какая клетка сокращается быстрее всего?
- Посмотрите на рисунок В. Как соотносятся упругие прыгающие инфузории с инфузориями плавающими?
- Каково распределение скоростей у прокариот?
- Сверхбыстрые клетки отображаются над сплошной линией, обозначающей 100 длин тела в секунду. Каковы наиболее распространенные типы сверхбыстрых клеток?
- Буква ”x» показывает приблизительную скорость снаряда, выпущенного из Ochromonas tuberculatus. С какой скоростью он движется (в пересчете на длину тела в секунду)?
Похожие истории
<литий class="виджет-пост-список-элемент__обертку___ZSRco пункт-2 С-образ-брови-флаг" роль="listitem элемент">  жизнь
жизнь
Давайте узнаем про микробов
по <промежуток class="виджет-пост-список-элемент__подпись___WfHtj автор визитную карточку">Сара Зелинский, что 20 июля 2021
<литий class="виджет-пост-список-элемент__обертку___ZSRco пункта-3 С-образ-брови-флаг" роль="listitem элемент"> жизнь
жизнь
бактерии окружают нас повсюду — и это нормально
по <промежуток class="виджет-пост-список-элемент__подпись___WfHtj автор визитную карточку">Линдси интриги NeaboreОктябрь 4, 2018

Добавить комментарий
Для отправки комментария вам необходимо авторизоваться.